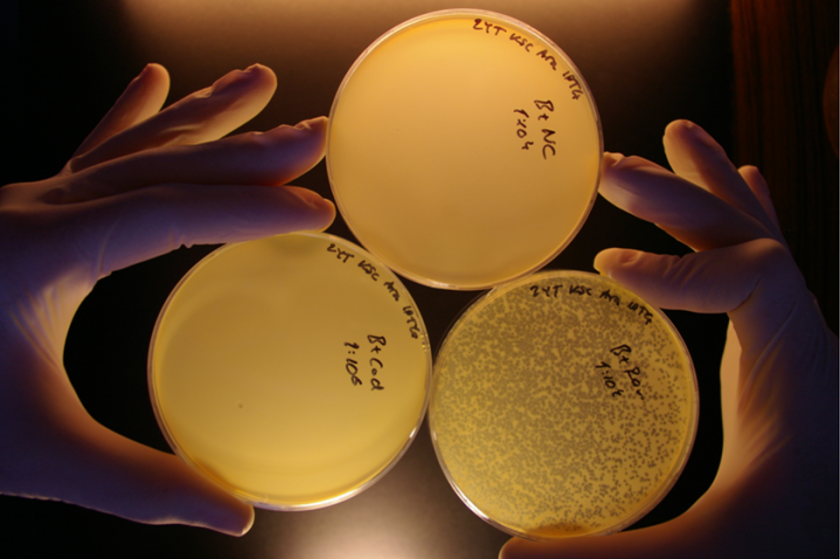
Eureka-moment tijdens CRISPR onderzoek in 2008

category_news
WUR geeft CRISPR intellectueel eigendomsrecht gratis weg in de strijd tegen honger
Het ultieme doel van plantenveredeling is altijd geweest om planten bestand te maken tegen droogte en ziekten. Dit kan helpen honger de wereld uit te bannen. Dankzij CRISPR-Cas technologie is dit niet langer een verre droom. Vandaag maakt Wageningen University & Research (WUR) bekend dat het potentiële partners gratis licenties gaat aanbieden waardoor zij kunnen werken met de door WUR gepatenteerde CRISPR-technologie. De licentie mag alleen gebruikt worden in plantenveredeling voor doelen zonder winstoogmerk. ‘Wij hopen hiermee bij te dragen aan een gezondere, duurzamere, rechtvaardigere en robuustere voedselproductie voor iedereen’, aldus WUR-voorzitter prof. dr. ir. Louise O. Fresco.
CRISPR-Cas is een technologie waarmee genetisch materiaal betrekkelijk eenvoudig en uiterst nauwkeurig en efficiënt kan worden aangepast. Wereldwijd zijn er zo’n 3,000 CRISPR-Cas patenten, waarvan WUR er enkele in handen heeft. Voor vijf van deze patenten, waarvan WUR en de NWO (Nederlandse Organisatie voor Wetenschappelijk Onderzoek) gezamenlijk eigenaar zijn, heeft WUR besloten gratis licenties beschikbaar te stellen. Direct na de bekendmaking verscheen over dit initiatief een artikel in Nature.
Waarom dit uniek is
Prof. Fresco: ‘Dit is echt behoorlijk uniek voor CRISPR, binnen de academische wereld en daarbuiten. Voor zover ons bekend, zijn wij één van de eersten die deze stap nemen met betrekking tot de CRISPR-technologie. Wij doen dit, omdat we sterk van mening zijn dat dit het juiste is om te doen.
- Helaas, uw cookie-instellingen zijn zodanig dat de Video niet getoond kan worden - pas uw permissie voor cookies aan
Prof. dr. ir. Louise Fresco kondigt het gratis eigendomsrecht aan.
Twee miljard mensen leden in 2020 onder een gebrek aan gezonde voeding. Bijna al deze mensen worden ook bedreigd door de effecten van klimaatverandering. We moeten dus toe naar een gezonder, duurzamer, rechtvaardiger, betaalbaarder en robuuster voedselsysteem. Dit staat ook centraal tijdens de UN Food Systems Summit op 23 september aanstaande. CRISPR en andere biowetenschappen kunnen deze transitie versnellen.
Ons initiatief past bovendien perfect binnen de missie van WUR: to explore the potential of nature to improve the quality of life. CRISPR, een bacterieel afweersysteem is een geweldig voorbeeld. Een WUR-team onder leiding van prof. Van der Oost is hier al sinds 2006 mee bezig.’
Mogelijkheden van CRISPR-Cas in de strijd tegen honger
Microbioloog prof. dr. John van der Oost is een van ‘s werelds voornaamste experts op het gebied van CRISPR-Cas. Hij wordt vaak gezien als een van de grondleggers van de technologie. Het vrijgeven van licenties gebeurt op zijn initiatief. Van der Oost: ‘De mogelijkheden van CRISPR-Cas kunnen niet genoeg benadrukt worden. Het is een buitengewone flexibele technologie waarmee nieuwe en duurzame methodes kunnen worden ontwikkeld om de groeiende wereldbevolking te voeden. We zijn blij dat we onze kennis kunnen delen voor dit doel, en we hopen dat meer patenthouders ons voorbeeld zullen volgen.’
Dr. Mohamed H.A. Hassan, President van de Academy of Science for the Developing World (TWAS) en voorzitter van de Raad van Bestuur van de United Nations Technology Bank for the Least Developed Countries (Verenigde Naties Technologiebank voor de Minst Ontwikkelde Landen) verwelkomt het besluit van Wageningen University & Research: ‘Het beschikbaar maken van deze licenties maakt snelle oplossingen voor een aantal urgente problemen in de Wereld mogelijk: de groeiende behoefte aan voeding en de impact van klimaatverandering en ziekteverwekkers. Ik verwacht dat non-profit organisaties en landbouw- en voedsel-onderzoeksinstituten in armere landen hier baat bij zullen hebben. Deze instituten zijn essentieel in het ontwikkelen van verbeterde gewassen voor menselijke en dierlijke consumptie voor plaatselijke boeren en arme consumenten. Zonder dit initiatief van WUR zouden zij niet in staat zijn geweest deze licenties te verkrijgen.’

Wetenschappelijke samenwerking rondom CRISPR
‘De CRISPR technologie kan alleen volledig benut worden door lange-termijn samenwerkingsverbanden en capaciteitsopbouw’, zegt prof. Fresco. ‘We willen graag leren van onze toekomstige CRISPR-partners en voortborduren op hun kennis. Samen kunnen we de manier waarop we omgaan met voedselzekerheid in de wereld veranderen. Daarom staan wij achter ons besluit deze kennis gratis beschikbaar te stellen in het kader van de Open Science beweging: datgene wat met publieke middelen is ontwikkeld beschikbaar maken voor het publiek.’
Marcel Levi, bestuursvoorzitter Nederlandse Organisatie voor Wetenschappelijk Onderzoek (NWO): ‘Het is fantastisch om te zien waar onderzoek toe kan leiden. Als NWO zijn we al sinds 2009 betrokken bij de ontwikkeling van deze revolutionaire toepassing van biotechnologie en als mede-octrooihouder maakt dat ons vandaag ook een klein beetje trots. Als groot voorstander van Open Science zijn we zeer verheugd dat de licenties beschikbaar worden gesteld voor een bijdrage aan een betere wereld. Kennis die met publiek geld is ontwikkeld, komt op deze manier terug in de samenleving. Wetenschap draagt hiermee bij aan het oplossen van een van de grote vraagstukken van deze tijd.’
Toevalstreffers
Dit initiatief werd bekendgemaakt tijdens de opening van het academisch jaar, waarvan ‘Crossing Boundaries’ (Grenzen Overschrijden) het thema was. In interviews voorafgaande aan de opening drong prof. Fresco aan op meer toevalstreffers en mislukkingen in de wetenschap: ‘Ik zie voor me dat we groepen veelbelovende wetenschappers samen gaan brengen zónder directe onderzoeksopdracht. De meest wilde ideeën zijn dan geoorloofd, net als meesterlijke mislukkingen. Toevallige ontdekkingen -waarvan CRISPR-Cas een voorbeeld is - komen alleen aan het licht als je ze ziet. We moeten de realiteit op verschillende manieren durven zien.’
Bekijk de video's over de Opening Academisch Jaar
- Helaas, uw cookie-instellingen zijn zodanig dat de Video niet getoond kan worden - pas uw permissie voor cookies aan
- Helaas, uw cookie-instellingen zijn zodanig dat de Video niet getoond kan worden - pas uw permissie voor cookies aan
- Helaas, uw cookie-instellingen zijn zodanig dat de Video niet getoond kan worden - pas uw permissie voor cookies aan
- Helaas, uw cookie-instellingen zijn zodanig dat de Video niet getoond kan worden - pas uw permissie voor cookies aan
- Helaas, uw cookie-instellingen zijn zodanig dat de Video niet getoond kan worden - pas uw permissie voor cookies aan
- Helaas, uw cookie-instellingen zijn zodanig dat de Video niet getoond kan worden - pas uw permissie voor cookies aan